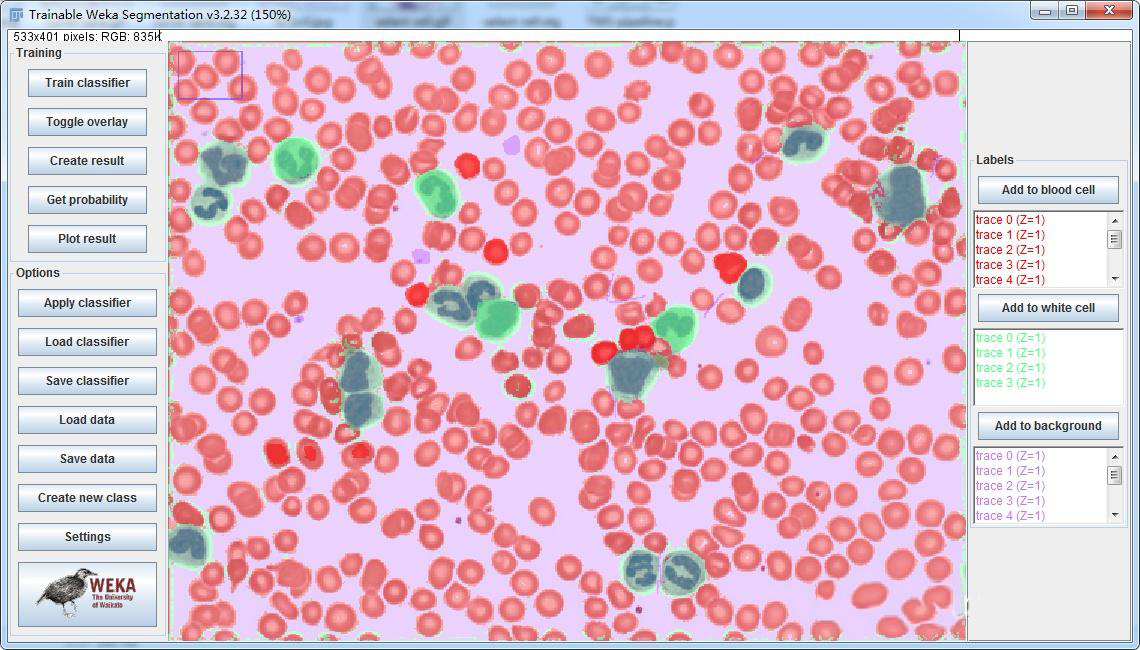
7.jpg

面积测量,是ImageJ中最常用的功能之一,之前的教程中没有对这一功能进行过多的说明。
而越来越多的同学在使用ImageJ测量面积时,出现了各式各样的问题。
这一篇文章会对怎样利用ImageJ进行面积测量做更为全面的叙述,包括手动、半自动和自动框选等类型,旨在让大家对面积测量有更深入的理解,掌握更多面积检测的方法,同时根据所举出的例子,找到适合自己的测量方法。
面积测量的Workflow很简单,只需要两步:
1、选出感兴趣的区域(ROI)——即图像分割
2、Measure
面积测量的本质其实就是图像的分割,图像分割的好坏直接决定了结果的好坏。
区域的框选又可以分为三种类型:
1、自动框选(Threshold、Analyze Particles、Color Threshold)
2、半自动框选(魔法棒工具、Trainable Weka Segmentation)
3、手动框选(矩形、圆形、Free hand工具等)
下面会对这三种类型逐一说明并举例:
第一步:告诉ImageJ你要测面积这一参数(Analyze -> Set Measurements)
在Set Measurements界面勾选Area。

情景一:自动框选(Threshold、Analyze Particles、Color Threshold)
1、整体面积(Image -> Adjust -> Threshold)
图像转为8-bit后,通过调整阈值,框选出细胞,然后Measure得到整体的面积。要求所选区域的灰度值,与周围区域有明显的差别。

2、单个细胞面积(Analyze -> Analyze Particles)
图像转为8-bit后,通过调整阈值,框选出细胞。如果细胞之间有重叠,还需要进行细胞分割。然后Analyze Particles,得到单个细胞的面积。

3、RGB彩色图像面积(Image -> Adjust -> Color Threshold)
对于RGB图像,通过颜色、饱和度、亮度等参数的调节,可以选取到颜色统一的区域。通常适用于免疫组化图像分析等。例如下图,通过调整Color Threshold可以选取到叶子深绿色的部分。

情景二:半自动框选(Wand tool、Trainable Weka Segmentation)
1、魔法棒工具(Wand tool)

利用魔法棒工具(Wand tool)中的图像分割算法,自动识别出区域边界,要求所选区域与周围区域具有明显的界限。
例如可以魔法棒工具勾选皮下脂肪,从而进行面积测量。

2、基于机器学习的自动细胞分割(Trainable Weka Segmentation)
Trainable Weka Segmentation是一款非常强大的插件,它集成了一系列机器学习算法,通过在同一张图片上学习不同细胞的特征,进行快速的2D/3D图像分割。
插件位置(Plugins -> Segmentation -> Trainable Weka Segmentation)
例如,可以利用Trainable Weka Segmentation分割不同的血细胞:
情景三:手动框选测量(各种框选工具)

利用矩形、圆形、多边形和Free Hand、Selection Brush Tool等工具,把想要测量的区域框选出来,然后Measure。面积测量的Golden rule其实还是手动框选。
该情景适用于所选区域与周围差别不大,无法利用上述自动框选出来的情况。例如下图无法利用调整阈值和魔法棒工具框选出每一层,需要利用Selection Brush Tool,框选出大脑切片的不同分区。

综上所述,面积测量的方法很多,需要多尝试才能找到最合适的。
实验外包 想了解更多请关注:http://www.do-gene.cn

